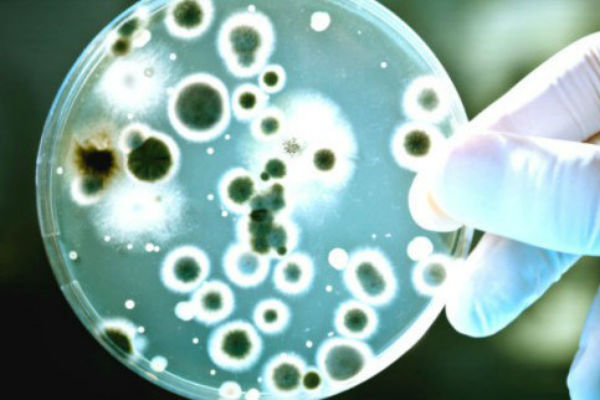

Na Balkan stigao strašan virus za koji ne postoji lijek: Ako imate ove simptome, odmah se javite doktoru
Tim hrvatskih doktora u ponedjeljak je u International Medical Case Reports Journalu objavio naučni članak na temu prvog slučaja Chikungunya groznice u Hrvatskoj, za koji se dosad nije znalo.
Iako se u medijima puno pisalo o virusnoj infekciji koja je slična Zika virusu, virusu Zapadnog Nila ili malariji kojeg prenose komarci, do sada nije bilo zabilježenog slučaja na ovim prostorima. Do sada.
Kako infektolozi Boris Lukšić i Nenad Pandak s još nekoliko kolega u svom naučnom radu pišu, 27-godišnja pacijentica prošle se godine vratila u Hrvatsku iz Costa Rice. Kući se vratila 21. marta 2016., nakon dva mjeseca boravka u egzotičnoj srednjoameričkoj državi, piše “Avaz“…
Dok je putovala kući, piše u članku, primijetila je da ima ugriz komarca na lijevoj podlaktici. Uporno joj se vraćala bol u zglobovima Pet dana kasnije, osjetila je sve glavne simptome Chikungunya groznice: bol u zglobovima, povišenu temperaturu te je primijetila crveni osip po udovima, dlanovima i stopalima. Tokom idućih nekoliko dana, simptomi su nestajali, ženi je nakon deset dana bilo bolje, međutim, vratila se bol u zglobovima te jutarnja ukočenost.
Chikungunya je groznica koja može trajati kratko, ali simptomi se mogu vratiti, posebno jaka bol u zglobovima koja može trajati i nekoliko mjeseci. Pacijentici je u krvi dijagnosticirana infekcija te je, kako pišu hrvatski stručnjaci, uslijedila terapija protivupalnim steroidima i paracetamolom, što je riješilo sve simptome, osim boli u zglobovima. Naime, ona se ponovno pojavila opet, tri mjeseca kasnije. Virus je teško sasvim ukloniti iz sistema To je poseban problem ovog virusa, teško ga je potpuno ukloniti iz sistema.
Doktori u svom članku ne spominju kako je mlada žean danas, ali napominju kako ovaj slučaj ukazuje na potrebu uključenja CHIKV-a u dijagnosticiranju artralgije kod svih putnika koji se vraćaju iz zemalja s dokumentiranom zarazom Chikungunyje.
Chikungunya je virusna zaraza koja izaziva višednevnu, često i višesedmičnu groznicu, a prenosi se ugrizima tigrastih komaraca. Nekada je bila izolovana za područja suptropske Afrike, Azije i Bliskog Istoka, prije tri godine virus se počeo širiti SAD-om i Evropom, a prošle godine došao je i na Balkan
Nema vakcine protiv ove bolesti
Ipak, valja naglasiti da je u prosjeku zabilježen jedan smrtni slučaj na hiljadu zaraženih. Liječenje protivupalnim steroidima otkloni sve najjače simptome, ali bol u zglobovima može biti dugotrajna, i vraćati se mjesecima nakon liječenja.
Najugroženije grupe su djeca, starci i osobe slabijeg imuniteta. Idealan tretman ne postoji.
Nema vakcine protiv ove bolesti. Postoje metode liječenja koje ublažuju ili otklanjaju simptome, ali naučnici i dalje traže pravo rješenje. Ono što vi možete napraviti jeste pravilno zaštiti se od komaraca, bez obzira na to putujete li negdje daleko, ili ostajete kući.
Izvor: avaz